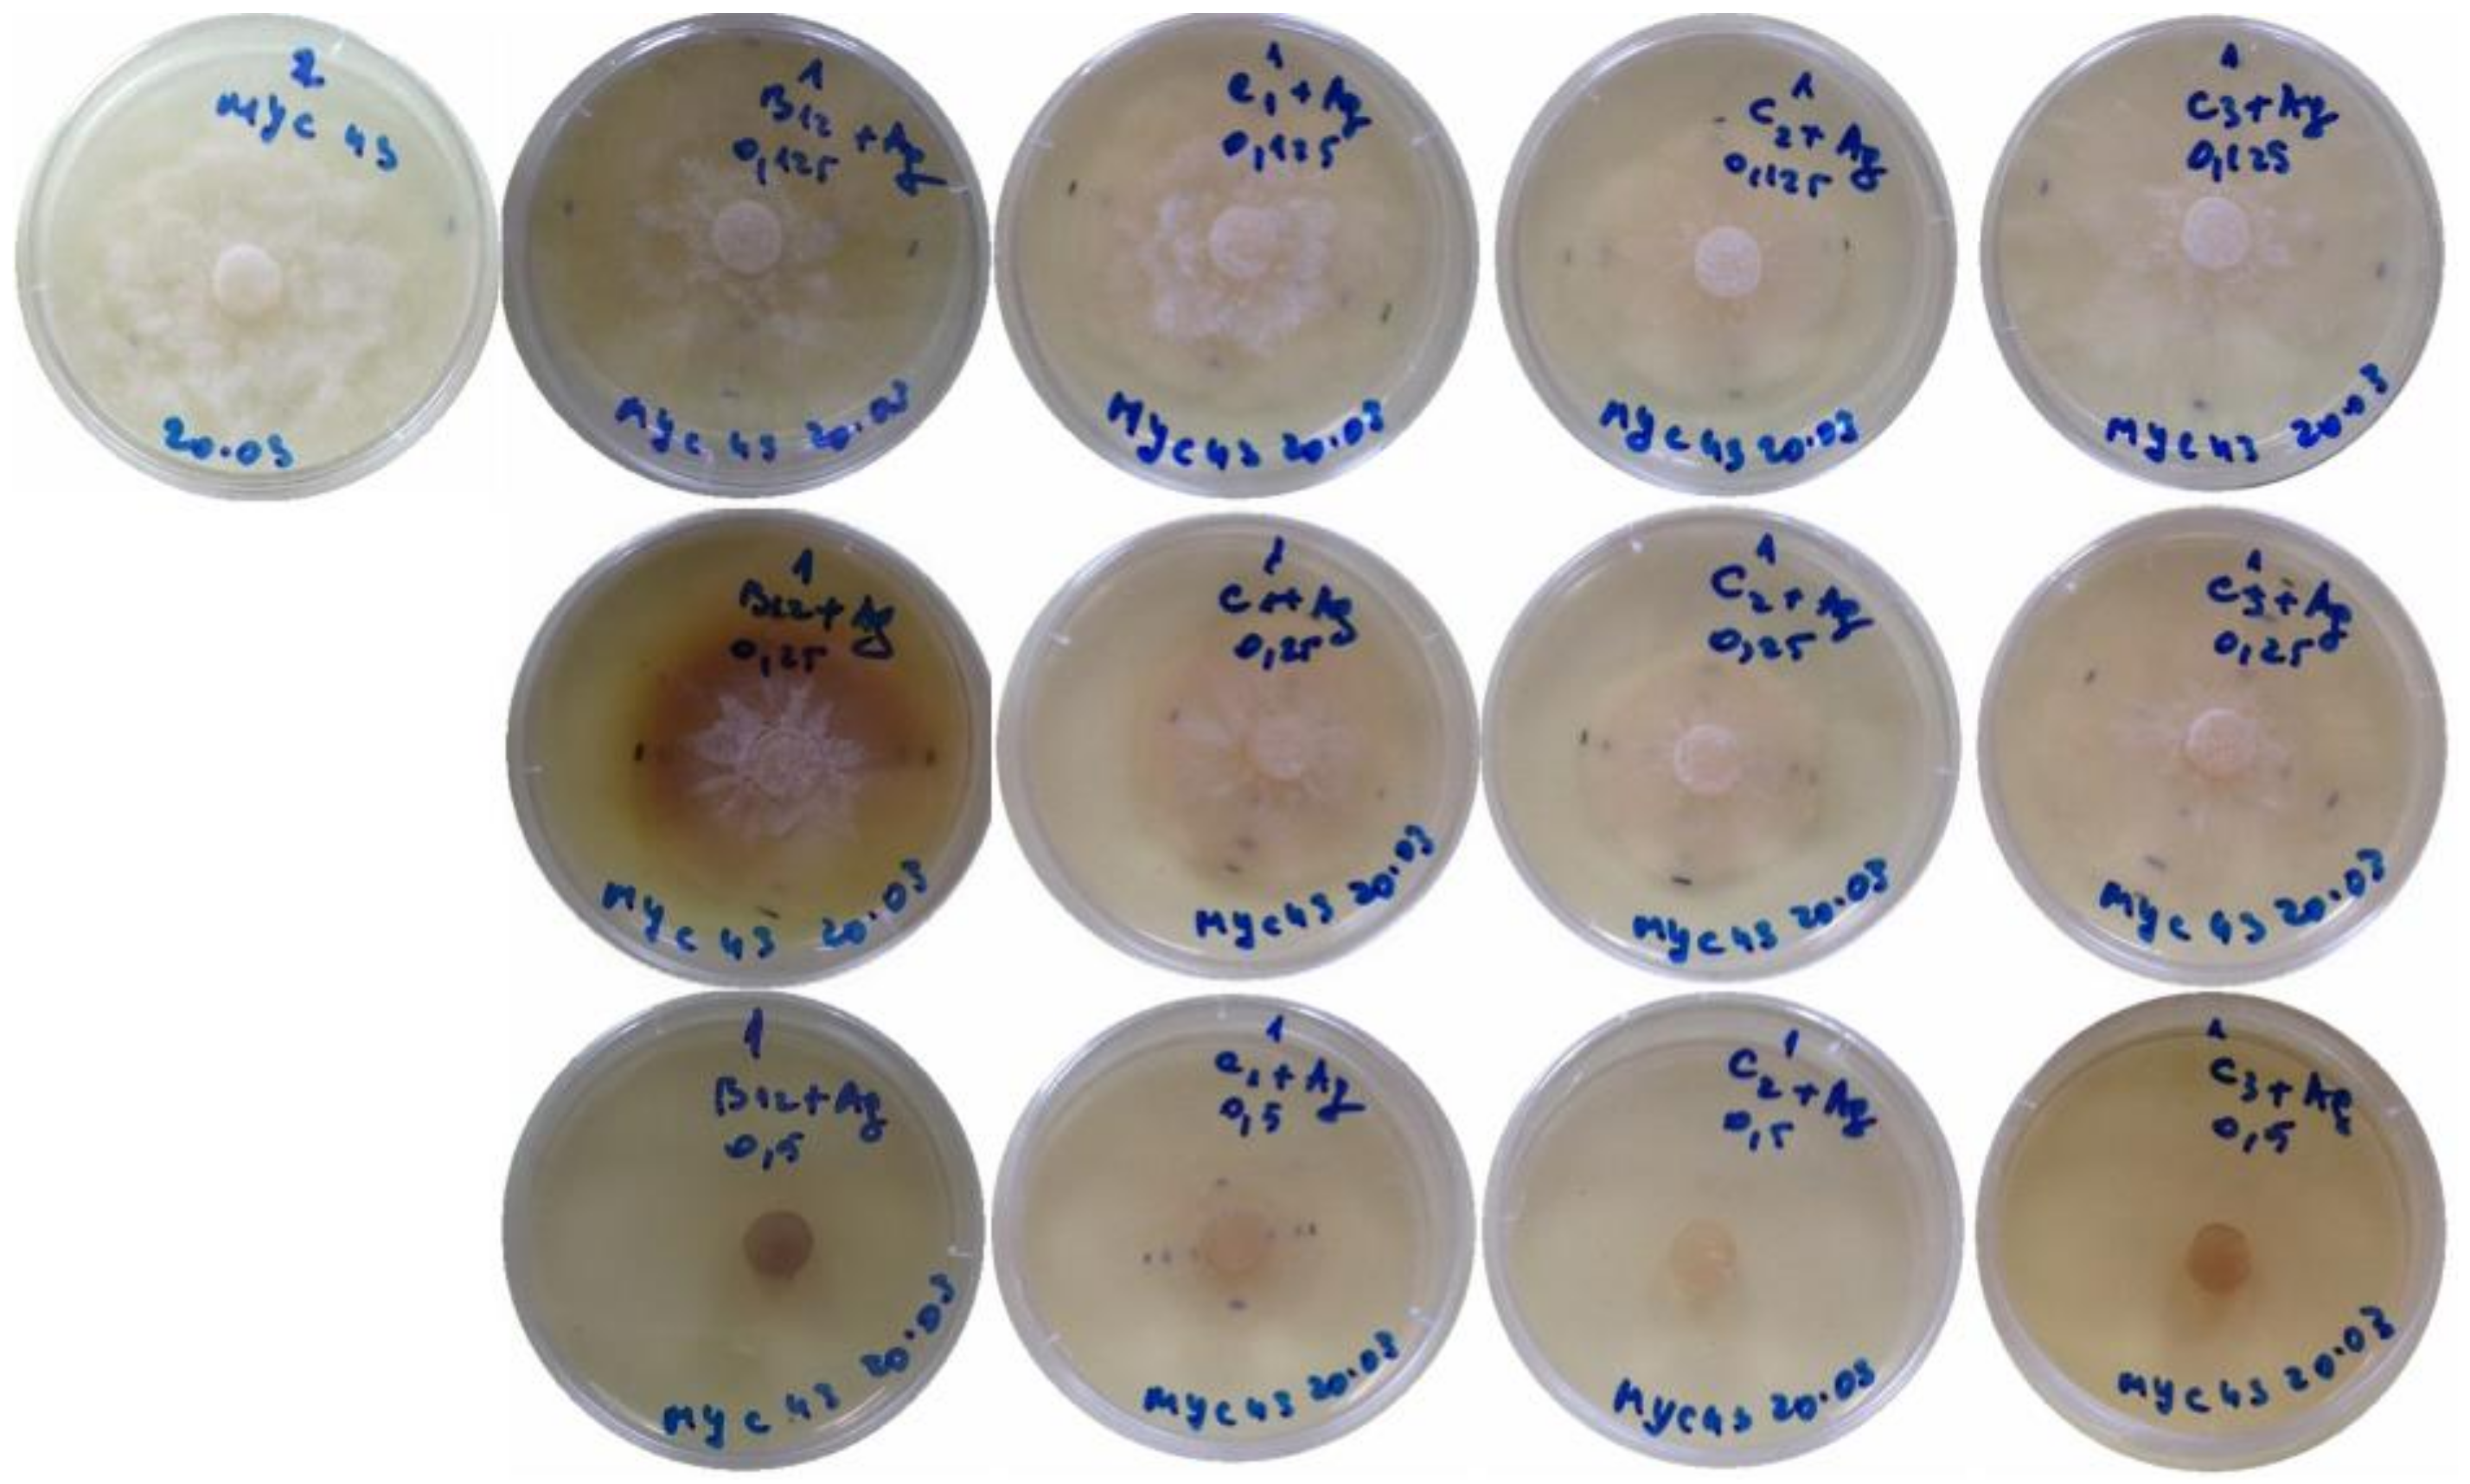
Antibiotics 07 00076 g001 Antibiotics 07 00076 g001
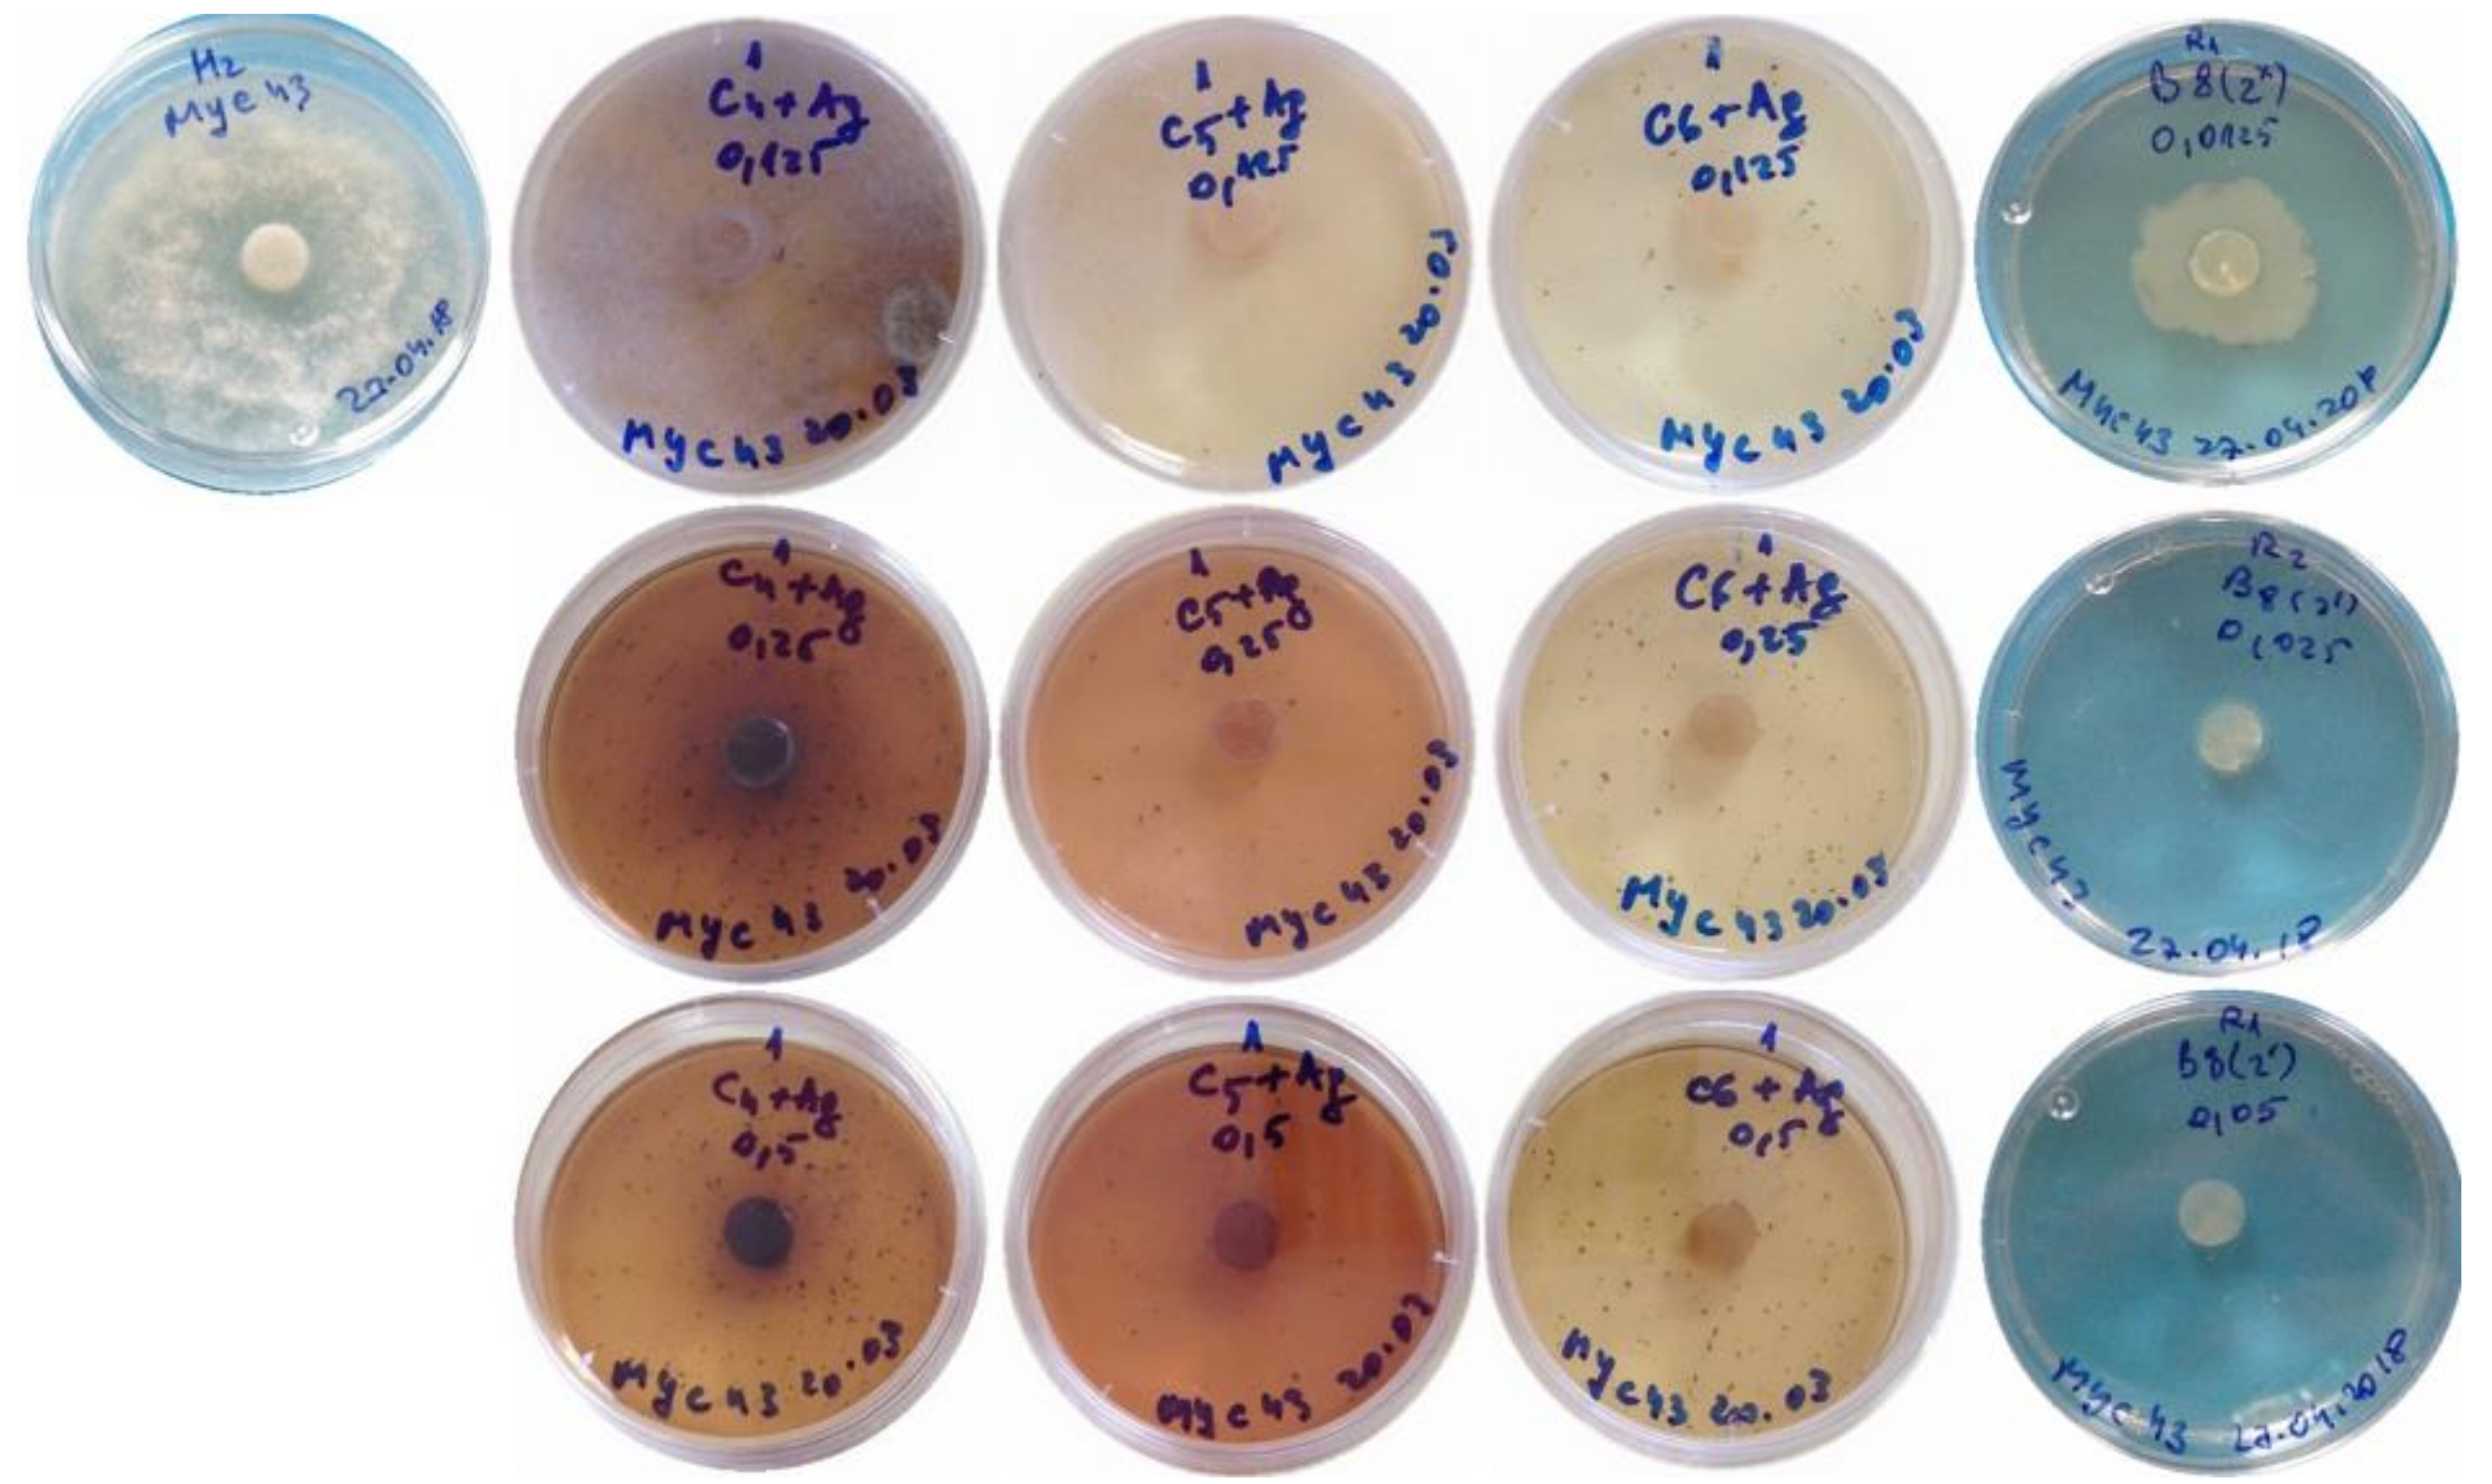
Antibiotics 07 00076 g002 Antibiotics 07 00076 g002

Silver Nanoparticles and Polyphenol Inclusion Compounds Composites for Phytophthora cinnamomi Mycelial Growth Inhibition
Abstract
1. Introduction
2. Results
3. Discussion
4. Materials and Methods
4.1. Reagents
4.2. Microwave-Assisted Preparation of the Polyphenol Inclusion Compounds
4.3. Chitosan Oligomers (COS)-Based Composites
4.4. Deep Eutectic Solvent-Based Composites
4.5. Silver Nanoparticles-Only Treatments
4.6. Characterization of the Nanocomposites
4.7. Fungal Isolates and Growth Conditions
4.8. Efficacy of the Nanocomposites for the Control of Phytophthora cinnamomi
5. Conclusions
6. Patents
Author Contributions
Funding
Acknowledgments
Conflicts of Interest
References
- Kim, D.-Y.; Kadam, A.; Shinde, S.; Saratale, R.G.; Patra, J.; Ghodake, G. Recent developments in nanotechnology transforming the agricultural sector: A transition replete with opportunities. J. Sci. Food Agric. 2018, 98, 849–864. [Google Scholar] [CrossRef] [PubMed]
- Berger, T.J.; Spadaro, J.A.; Chapin, S.E.; Becker, R.O. Electrically generated silver ions: Quantitative effects on bacterial and mammalian cells. Antimicrob. Agents Chemother. 1976, 9, 357–358. [Google Scholar] [CrossRef] [PubMed]
- Xia, Z.-K.; Ma, Q.-H.; Li, S.-Y.; Zhang, D.-Q.; Cong, L.; Tian, Y.-L.; Yang, R.-Y. The antifungal effect of silver nanoparticles on Trichosporon asahii. J. Microbiol. Immunol. Infect. 2016, 49, 182–188. [Google Scholar] [CrossRef] [PubMed]
- Kim, S.W.; Jung, J.H.; Lamsal, K.; Kim, Y.S.; Min, J.S.; Lee, Y.S. Antifungal effects of silver nanoparticles (AgNPs) against various plant pathogenic fungi. Mycobiology 2018, 40, 53–58. [Google Scholar] [CrossRef] [PubMed]
- Kharissova, O.V.; Dias, H.V.R.; Kharisov, B.I.; Pérez, B.O.; Jiménez Pérez, V.M. The greener synthesis of nanoparticles. Trends Biotechnol. 2013, 31, 240–248. [Google Scholar] [CrossRef] [PubMed]
- Rajan, R.; Chandran, K.; Harper, S.L.; Yun, S.-I.; Kalaichelvan, P.T. Plant extract synthesized silver nanoparticles: An ongoing source of novel biocompatible materials. Ind. Crop. Prod. 2015, 70, 356–373. [Google Scholar] [CrossRef]
- Bujak, T.; Nizioł-Łukaszewska, Z.; Gaweł-Bęben, K.; Seweryn, A.; Kucharek, M.; Rybczyńska-Tkaczyk, K.; Matysiak, M. The application of different Stevia rebaudiana leaf extracts in the “green synthesis” of AgNPs. Green Chem. Lett. Rev. 2015, 8, 78–87. [Google Scholar] [CrossRef]
- Sathishkumar, M.; Sneha, K.; Yun, Y.-S. Immobilization of silver nanoparticles synthesized using Curcuma longa tuber powder and extract on cotton cloth for bactericidal activity. Bioresour. Technol. 2010, 101, 7958–7965. [Google Scholar] [CrossRef] [PubMed]
- Raut, R.W.; Kolekar, N.S.; Lakkakula, J.R.; Mendhulkar, V.D.; Kashid, S.B. Extracellular synthesis of silver nanoparticles using dried leaves of Pongamia pinnata (L.) Pierre. Nano Micro Lett. 2010, 2, 106–113. [Google Scholar] [CrossRef]
- Raut, W.; Lakkakula, R.; Kolekar, S.; Mendhulkar, D.; Kashid, B. Phytosynthesis of silver nanoparticle using Gliricidia sepium (Jacq.). Curr. Nanosci. 2009, 5, 117–122. [Google Scholar]
- Rahimi-Nasrabadi, M.; Pourmortazavi, S.M.; Shandiz, S.A.S.; Ahmadi, F.; Batooli, H. Green synthesis of silver nanoparticles using Eucalyptus leucoxylon leaves extract and evaluating the antioxidant activities of extract. Nat. Prod. Res. 2014, 28, 1964–1969. [Google Scholar] [CrossRef] [PubMed]
- Safaei, H.R. Eco-friendly method for green recovery of silver nano particles from effluent fixer solution through interacting with Q. brantii (oak) peel hydro alcoholic extract. J. Adv. Eng. Technol. 2017, 5, 1–7. [Google Scholar]
- Li, D.; Liu, Z.; Yuan, Y.; Liu, Y.; Niu, F. Green synthesis of gallic acid-coated silver nanoparticles with high antimicrobial activity and low cytotoxicity to normal cells. Process Biochem. 2015, 50, 357–366. [Google Scholar] [CrossRef]
- Safarpoor, M.; Ghaedi, M.; Asfaram, A.; Yousefi-Nejad, M.; Javadian, H.; Zare Khafri, H.; Bagherinasab, M. Ultrasound-assisted extraction of antimicrobial compounds from Thymus daenensis and Silybum marianum: Antimicrobial activity with and without the presence of natural silver nanoparticles. Ultrason. Sonochem. 2018, 42, 76–83. [Google Scholar] [CrossRef] [PubMed]
- Alves, T.F.; Chaud, M.V.; Grotto, D.; Jozala, A.F.; Pandit, R.; Rai, M.; dos Santos, C.A. Association of silver nanoparticles and curcumin solid dispersion: Antimicrobial and antioxidant properties. AAPS PharmSciTech 2017, 19, 225–231. [Google Scholar] [CrossRef] [PubMed]
- Hussain, Z.; Thu, H.E.; Amjad, M.W.; Hussain, F.; Ahmed, T.A.; Khan, S. Exploring recent developments to improve antioxidant, anti-inflammatory and antimicrobial efficacy of curcumin: A review of new trends and future perspectives. Mater. Sci. Eng. C 2017, 77, 1316–1326. [Google Scholar] [CrossRef] [PubMed]
- Oliver, S.; Vittorio, O.; Cirillo, G.; Boyer, C. Enhancing the therapeutic effects of polyphenols with macromolecules. Polym. Chem. 2016, 7, 1529–1544. [Google Scholar] [CrossRef]
- Liu, J.; Pu, H.; Liu, S.; Kan, J.; Jin, C. Synthesis, characterization, bioactivity and potential application of phenolic acid grafted chitosan: A review. Carbohydr. Polym. 2017, 174, 999–1017. [Google Scholar] [CrossRef] [PubMed]
- Hashemi Gahruie, H.; Niakousari, M. Antioxidant, antimicrobial, cell viability and enzymatic inhibitory of antioxidant polymers as biological macromolecules. Int. J. Biol. Macromol. 2017, 104, 606–617. [Google Scholar] [CrossRef] [PubMed]
- Saranya, T.S.; Rajan, V.K.; Biswas, R.; Jayakumar, R.; Sathianarayanan, S. Synthesis, characterisation and biomedical applications of curcumin conjugated chitosan microspheres. Int. J. Biol. Macromol. 2018, 110, 227–233. [Google Scholar] [CrossRef] [PubMed]
- Bajpai, S.K.; Ahuja, S.; Chand, N.; Bajpai, M. Nano cellulose dispersed chitosan film with Ag NPs/curcumin: An in vivo study on albino rats for wound dressing. Int. J. Biol. Macromol. 2017, 104, 1012–1019. [Google Scholar] [CrossRef] [PubMed]
- Barbinta-Patrascu, M.E.; Badea, N.; Pirvu, C.; Bacalum, M.; Ungureanu, C.; Nadejde, P.L.; Ion, C.; Rau, I. Multifunctional soft hybrid bio-platforms based on nano-silver and natural compounds. Mater. Sci. Eng. C 2016, 69, 922–932. [Google Scholar] [CrossRef] [PubMed]
- Nguyen, T.T.H.; Si, J.; Kang, C.; Chung, B.; Chung, D.; Kim, D. Facile preparation of water soluble curcuminoids extracted from turmeric (Curcuma longa L.) powder by using steviol glucosides. Food Chem. 2017, 214, 366–373. [Google Scholar] [CrossRef] [PubMed]
- Kadota, K.; Okamoto, D.; Sato, H.; Onoue, S.; Otsu, S.; Tozuka, Y. Hybridization of polyvinylpyrrolidone to a binary composite of curcumin/α-glucosyl stevia improves both oral absorption and photochemical stability of curcumin. Food Chem. 2016, 213, 668–674. [Google Scholar] [CrossRef] [PubMed]
- Ruesgas-Ramón, M.; Figueroa-Espinoza, M.C.; Durand, E. Application of deep eutectic solvents (DES) for phenolic compounds extraction: Overview, challenges, and opportunities. J. Agric. Food. Chem. 2017, 65, 3591–3601. [Google Scholar] [CrossRef] [PubMed]
- Georgantzi, C.; Lioliou, A.-E.; Paterakis, N.; Makris, D. Combination of lactic acid-based deep eutectic solvents (DES) with β-cyclodextrin: Performance screening using ultrasound-assisted extraction of polyphenols from selected native Greek medicinal plants. Agronomy 2017, 7, 54. [Google Scholar] [CrossRef]
- Almeida, C.M.R.; Magalhães, J.M.C.S.; Souza, H.K.S.; Gonçalves, M.P. The role of choline chloride-based deep eutectic solvent and curcumin on chitosan films properties. Food Hydrocoll. 2018, 81, 456–466. [Google Scholar] [CrossRef]
- Pereira, P.F.; Andrade, C.T. Optimized pH-responsive film based on a eutectic mixture-plasticized chitosan. Carbohydr. Polym. 2017, 165, 238–246. [Google Scholar] [CrossRef] [PubMed]
- Kroon, L.P.N.M.; Brouwer, H.; de Cock, A.W.A.M.; Govers, F. The genus Phytophthora anno 2012. Phytopathology 2012, 102, 348–364. [Google Scholar] [CrossRef] [PubMed]
- Munnecke, D.E. Establishment of micro-organisms in fumigated avocado soil to attempt to prevent reinvasion of the soils by Phytophthora cinnamomi. Trans. Br. Mycol. Soc. 1984, 83, 287–294. [Google Scholar] [CrossRef]
- Zentmyer, G.A. The world of Phytophthora. In Phytophthora, Its biology, Taxonomy, Ecology and Pathology; Erwin, D.C., Bartnicki-García, S., Tsao, P.H., Eds.; American Phytopathological Society: St. Paul, MN, USA, 1983; pp. 1–8. [Google Scholar]
- Ali, M.; Kim, B.; Belfield, K.D.; Norman, D.; Brennan, M.; Ali, G.S. Inhibition of Phytophthora parasitica and P. capsici by silver nanoparticles synthesized using aqueous extract of Artemisia absinthium. Phytopathology 2015, 105, 1183–1190. [Google Scholar] [CrossRef] [PubMed]
- Atia, M.M.M.; Buchenauer, H.; Aly, A.Z.; Abou-Zaid, M.I. Antifungal activity of chitosan against Phytophthora infestans and activation of defence mechanisms in tomato to late blight. Biol. Agric. Hortic. 2005, 23, 175–197. [Google Scholar] [CrossRef]
- Wang, L.-S.; Wang, C.-Y.; Yang, C.-H.; Hsieh, C.-L.; Chen, S.-Y.; Shen, C.-Y.; Wang, J.-J.; Huang, K.-S. Synthesis and anti-fungal effect of silver nanoparticles-chitosan composite particles. Int. J. Nanomed. 2015, 10, 2685–2696. [Google Scholar]
- Silva-Castro, I.; Martín-García, J.; Diez, J.J.; Flores-Pacheco, J.A.; Martín-Gil, J.; Martín-Ramos, P. Potential control of forest diseases by solutions of chitosan oligomers, propolis and nanosilver. Eur. J. Plant Pathol. 2017, 150, 401–411. [Google Scholar] [CrossRef]
- Martín-Gil, J.; Matei Petruta, M.; Pérez Lebeña, E. Complejo de inclusión para mejorar la biodisponibilidad de compuestos biológicamente activos no hidrosolubles. P201731489, 28 December 2017. [Google Scholar]
- Kim, M.K.; Choi, G.J.; Lee, H.S. Fungicidal property of Curcuma longa L. rhizome-derived curcumin against phytopathogenic fungi in a greenhouse. J. Agric. Food Chem. 2003, 51, 1578–1581. [Google Scholar] [CrossRef] [PubMed]
- Pompimon, W.; Jomduang, J.; Prawat, U.; Mankhetkorn, S. Anti-Phytopthora capsici activities and potential use as antifungal in agriculture of Alpinia galanga Swartz, Curcuma longa Linn, Boesenbergia pandurata Schut and Chromolaena odorata: Bioactivities guided isolation of active ingredients. Am. J. Agric. Biol. Sci. 2009, 4, 83–91. [Google Scholar] [CrossRef]
- Hu, L.-F.; Chen, C.-Z.; Yi, X.-H.; Feng, J.-T.; Zhang, X. Inhibition of p-isopropyl benzaldehyde and p-isopropyl benzoic acid extracted from Cuminum cyminum against plant pathogens. Acta Bot. Boreal. Occident. Sin. 2008, 11, 42. [Google Scholar]
- Shim, S.-H.; Kim, J.-C.; Jang, K.-S.; Choi, G.-J. Anti-oomycete activity of furanocoumarins from seeds of Psoralea corylifolia against Phytophthora infestans. Plant Pathol. J. 2009, 25, 103–107. [Google Scholar] [CrossRef]
- Krutyakov, Y.A.; Kudrinskiy, A.A.; Zherebin, P.M.; Yapryntsev, A.D.; Pobedinskaya, M.A.; Elansky, S.N.; Denisov, A.N.; Mikhaylov, D.M.; Lisichkin, G.V. Tallow amphopolycarboxyglycinate-stabilized silver nanoparticles: New frontiers in development of plant protection products with a broad spectrum of action against phytopathogens. Mater. Res. Express 2016, 3, 1–9. [Google Scholar] [CrossRef]
- Banik, S.; Pérez-de-Luque, A. In vitro effects of copper nanoparticles on plant pathogens, beneficial microbes and crop plants. Span. J. Agric. Res. 2017, 15. [Google Scholar] [CrossRef]
- Ostaszewska, T.; Chojnacki, M.; Kamaszewski, M.; Sawosz-Chwalibóg, E. Histopathological effects of silver and copper nanoparticles on the epidermis, gills, and liver of Siberian sturgeon. Environ. Sci. Pollut. Res. 2015, 23, 1621–1633. [Google Scholar] [CrossRef] [PubMed]
- Dobrochna, A.; Jerzy, S.; Teresa, O.; Magda, F.; Malgorzata, R.; Yuichiro, M.; Kacper, M. Effect of copper and silver nanoparticles on trunk muscles in rainbow trout (Oncorhynchus mykiss, Walbaum, 1792). Turk. J. Fish. Aquat. Sci. 2018, 18, 781–788. [Google Scholar] [CrossRef]
- Badawy, M.E.I.; Rabea, E.I. Synthesis and antimicrobial activity of N-(6-carboxyl cyclohex-3-ene carbonyl) chitosan with different degrees of substitution. Int. J. Carbohydr. Chem. 2016, 2016, 1–10. [Google Scholar] [CrossRef]
- Kim, K.-J.; Sung, W.S.; Suh, B.K.; Moon, S.-K.; Choi, J.-S.; Kim, J.G.; Lee, D.G. Antifungal activity and mode of action of silver nano-particles on Candida albicans. BioMetals 2008, 22, 235–242. [Google Scholar] [CrossRef] [PubMed]
- Clement, J.L.; Jarrett, P.S. Antibacterial silver. Met. Based Drugs 1994, 1, 467–482. [Google Scholar] [CrossRef] [PubMed]
- Zhang, J.; Higashi, K.; Ueda, K.; Kadota, K.; Tozuka, Y.; Limwikrant, W.; Yamamoto, K.; Moribe, K. Drug solubilization mechanism of α-glucosyl stevia by NMR spectroscopy. Int. J. Pharm. 2014, 465, 255–261. [Google Scholar] [CrossRef] [PubMed]
- Ferreira, F.D.; Mossini, S.A.G.; Ferreira, F.M.D.; Arrotéia, C.C.; da Costa, C.L.; Nakamura, C.V.; Machinski Junior, M. The inhibitory effects of Curcuma longa L. essential oil and curcumin on Aspergillus flavus Link growth and morphology. Sci. World J. 2013, 2013, 1–6. [Google Scholar] [CrossRef] [PubMed]
- Lee, W.; Lee, D.G. An antifungal mechanism of curcumin lies in membrane-targeted action within Candida albicans. IUBMB Life 2014, 66, 780–785. [Google Scholar] [CrossRef] [PubMed]
- Badhani, B.; Sharma, N.; Kakkar, R. Gallic acid: A versatile antioxidant with promising therapeutic and industrial applications. RSC Adv. 2015, 5, 27540–27557. [Google Scholar] [CrossRef]
- Ing, L.Y.; Zin, N.M.; Sarwar, A.; Katas, H. Antifungal activity of chitosan nanoparticles and correlation with their physical properties. Int. J. Biomater. 2012, 2012, 1–9. [Google Scholar] [CrossRef] [PubMed]
- Juneidi, I.; Hayyan, M.; Mohd Ali, O. Toxicity profile of choline chloride-based deep eutectic solvents for fungi and Cyprinus carpio fish. Environ. Sci. Pollut. Res. 2016, 23, 7648–7659. [Google Scholar] [CrossRef] [PubMed]
- Hayyan, M.; Hashim, M.A.; Al-Saadi, M.A.; Hayyan, A.; AlNashef, I.M.; Mirghani, M.E.S. Assessment of cytotoxicity and toxicity for phosphonium-based deep eutectic solvents. Chemosphere 2013, 93, 455–459. [Google Scholar] [CrossRef] [PubMed]
- Radošević, K.; Čanak, I.; Panić, M.; Markov, K.; Bubalo, M.C.; Frece, J.; Srček, V.G.; Redovniković, I.R. Antimicrobial, cytotoxic and antioxidative evaluation of natural deep eutectic solvents. Environ. Sci. Pollut. Res. 2018, 25, 14188–14196. [Google Scholar] [CrossRef] [PubMed]
- Papaccio, G.; Hayyan, M.; Looi, C.Y.; Hayyan, A.; Wong, W.F.; Hashim, M.A. In vitro and in vivo toxicity profiling of ammonium-based deep eutectic solvents. PLoS ONE 2015, 10. [Google Scholar] [CrossRef]
- Mbous, Y.P.; Hayyan, M.; Wong, W.F.; Looi, C.Y.; Hashim, M.A. Unraveling the cytotoxicity and metabolic pathways of binary natural deep eutectic solvent systems. Sci. Rep. 2017, 7. [Google Scholar] [CrossRef] [PubMed]
- Wikene, K.O.; Rukke, H.V.; Bruzell, E.; Tønnesen, H.H. Investigation of the antimicrobial effect of natural deep eutectic solvents (NADES) as solvents in antimicrobial photodynamic therapy. J. Photochem. Photobiol. B Biol. 2017, 171, 27–33. [Google Scholar] [CrossRef] [PubMed]
- Fan, Y.; Li, X.; Yan, L.; Li, J.; Hua, S.; Song, L.; Wang, R.; Sha, S. Enhanced extraction of antioxidants from aqueous solutions by ionic liquids. Sep. Purif. Technol. 2017, 172, 480–488. [Google Scholar] [CrossRef]
- Sun, T.; Zhou, D.; Xie, J.; Mao, F. Preparation of chitosan oligomers and their antioxidant activity. Eur. Food Res. Technol. 2007, 225, 451–456. [Google Scholar] [CrossRef]
- Biswas, A.; Shogren, R.L.; Stevenson, D.G.; Willett, J.L.; Bhowmik, P.K. Ionic liquids as solvents for biopolymers: Acylation of starch and zein protein. Carbohydr. Polym. 2006, 66, 546–550. [Google Scholar] [CrossRef]
- Raja, S.; Murty, V.R.; Thivaharan, V.; Rajasekar, V.; Ramesh, V. Aqueous two phase systems for the recovery of biomolecules—A review. Sci. Technol. 2012, 1, 7–16. [Google Scholar] [CrossRef]
- Şesan, T.E.; Enache, E.; Iacomi, B.M.; Oprea, M.; Oancea, F.; Iacomi, C. In vitro antifungal activity of some plant extracts against Fusarium oxysporum in blackcurrant (Ribes nigrum L.). Acta Sci. Pol. Hortorum Cultus 2017, 16, 167–176. [Google Scholar] [CrossRef]

| Treatment | EC50 (µg·mL−1) | EC90 (µg·mL−1) |
|---|---|---|
| COS AgNPs | 458.4 | 1192.8 |
| COS Gallic acid | 261.3 | 455.6 |
| COS Silymarin | 261.8 | 963.7 |
| COS Ferulic acid | 171.6 | 450.4 |
| COS Curcumin | 279.9 | 487.4 |
| DES AgNPs | 13.3 | 253.3 |
| DES Gallic acid | 0.1 | 77.9 |
| DES Silymarin | 0.6 | 107.8 |
| DES Ferulic acid | 0.6 | 107.8 |
| DES Curcumin | 8.9 | 184.3 |
© 2018 by the authors. Licensee MDPI, Basel, Switzerland. This article is an open access article distributed under the terms and conditions of the Creative Commons Attribution (CC BY) license (http://creativecommons.org/licenses/by/4.0/).
Share and Cite
Matei, P.M.; Martín-Gil, J.; Michaela Iacomi, B.; Pérez-Lebeña, E.; Barrio-Arredondo, M.T.; Martín-Ramos, P. Silver Nanoparticles and Polyphenol Inclusion Compounds Composites for Phytophthora cinnamomi Mycelial Growth Inhibition. Antibiotics 2018, 7, 76. https://doi.org/10.3390/antibiotics7030076
Matei PM, Martín-Gil J, Michaela Iacomi B, Pérez-Lebeña E, Barrio-Arredondo MT, Martín-Ramos P. Silver Nanoparticles and Polyphenol Inclusion Compounds Composites for Phytophthora cinnamomi Mycelial Growth Inhibition. Antibiotics. 2018; 7(3):76. https://doi.org/10.3390/antibiotics7030076
Chicago/Turabian StyleMatei, Petruta Mihaela, Jesús Martín-Gil, Beatrice Michaela Iacomi, Eduardo Pérez-Lebeña, María Teresa Barrio-Arredondo, and Pablo Martín-Ramos. 2018. "Silver Nanoparticles and Polyphenol Inclusion Compounds Composites for Phytophthora cinnamomi Mycelial Growth Inhibition" Antibiotics 7, no. 3: 76. https://doi.org/10.3390/antibiotics7030076
APA StyleMatei, P. M., Martín-Gil, J., Michaela Iacomi, B., Pérez-Lebeña, E., Barrio-Arredondo, M. T., & Martín-Ramos, P. (2018). Silver Nanoparticles and Polyphenol Inclusion Compounds Composites for Phytophthora cinnamomi Mycelial Growth Inhibition. Antibiotics, 7(3), 76. https://doi.org/10.3390/antibiotics7030076

